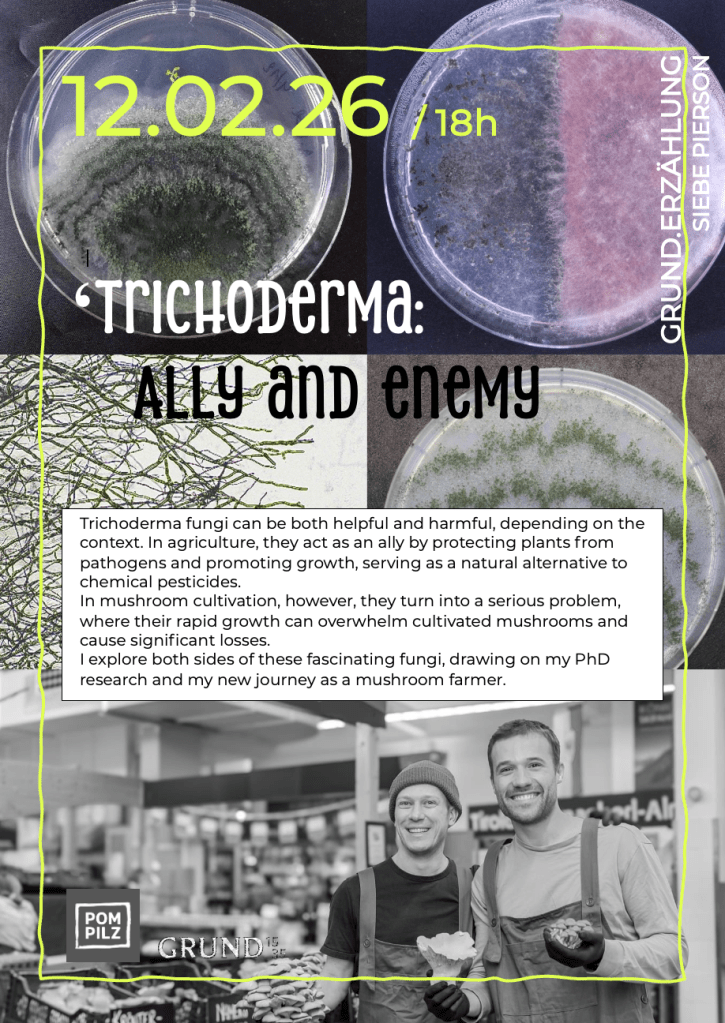

12.02.26 / 18h @ GRUND1535
„Trichoderma: Ally and enemy “
by Siebe Pierson, PhD
(Microbiologist / University of Innsbruck)








abstract:
Trichoderma fungi can be both helpful and harmful, depending on the context. In agriculture, they act as an ally by protecting plants from pathogens and promoting growth, serving as a natural alternative to chemical pesticides.
In mushroom cultivation, however, they turn into a serious problem, where their rapid growth can overwhelm cultivated mushrooms and cause significant losses.
I explore both sides of these fascinating fungi, drawing on my PhD research and my new journey as a mushroom farmer.
bio:
Siebe Pierson

completed his Bachelor and Master Biochemistry and Biotechnology at KU Leuven in Belgium. Afterwards he moved to Innsbruck and started his PhD at Universität Innsbruck in the department of Microbiology which he finished this year. He is now part of Pompilz, an urban mushroom farm in Innsbruck that produces gourmet mushrooms.
